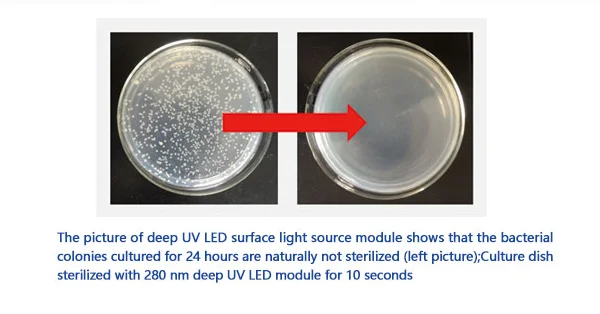

UV Germicidal 222 265 275nm LED Running Water Sterilizer Sterilization UVC Module Ultral Violet water reactor
- Category: >>>
- Supplier: Shenzhen Lanju Technology Co. Ltd.
Share on (1600313795131):
Product Overview
Description

Specification
item | value |
Type | UV LED |
Place of Origin | China |
Brand Name | raysr |
Certification | Ce, RoHS |
Wavelength | 275nm |
Packing & Delivery




To better ensure the safety of your goods, professional, environmentally friendly, convenient and efficient packaging services will be provided.
Company Profile






Uvnovo belongs to the Raysr Group and is a national high-tech enterprise focusing on UV LED sterilization and light curing systems. It has 15 years of R&D and production management experience in the LED industry, and has obtained more than 40 patents and intellectual property rights. With independent research and development capabilities, with thermal, optical, electronic, structural, and software engineers, we can provide customized developing service to customers. Uvnovo has a clean production workshop of 3000 square meters, full-automatic SMT and reflow soldering equipment. The company has passed the audit of ISO9001 and ISO14001.
Uvnovo's sterilization products have a sterilization efficiency of over 99.99%, focusing on the sterilization effect while paying attention to the protection of users. The light curing system has installed more than 50 printing presses in China. Uvnovo products withstood the test of customers' long-term and rigorous use environment, the quality is reliable and well received by customers. Uvnovo aims to become an internationally advanced enterprise in the UV LED industry, providing customers with updated and better products and services.
FAQ
1. who are we?
We are based in Guangdong, China, start from 2015,sell to Domestic Market(70.00%),Eastern Asia(10.00%),Eastern Europe(10.00%),North America(10.00%). There are total about 51-100 people in our office.
2. how can we guarantee quality?
Always a pre-production sample before mass production;
Always final Inspection before shipment;
3.what can you buy from us?
UV LED module,UVC LED,UV LED sterilizer,Ultraviolet LED,UV LED PCBA
4. why should you buy from us not from other suppliers?
ISO9001, ISO14001; 18 years LED experience; R&D capability; Own SMT and production lines Own factory and plant.
5. what services can we provide?
Accepted Delivery Terms: FOB,CFR,CIF,EXW,Express Delivery;
Accepted Payment Currency:USD,EUR,JPY,CAD,AUD,HKD,GBP,CNY,CHF;
Accepted Payment Type: T/T,PayPal,Cash;
Language Spoken:English,Chinese
We are based in Guangdong, China, start from 2015,sell to Domestic Market(70.00%),Eastern Asia(10.00%),Eastern Europe(10.00%),North America(10.00%). There are total about 51-100 people in our office.
2. how can we guarantee quality?
Always a pre-production sample before mass production;
Always final Inspection before shipment;
3.what can you buy from us?
UV LED module,UVC LED,UV LED sterilizer,Ultraviolet LED,UV LED PCBA
4. why should you buy from us not from other suppliers?
ISO9001, ISO14001; 18 years LED experience; R&D capability; Own SMT and production lines Own factory and plant.
5. what services can we provide?
Accepted Delivery Terms: FOB,CFR,CIF,EXW,Express Delivery;
Accepted Payment Currency:USD,EUR,JPY,CAD,AUD,HKD,GBP,CNY,CHF;
Accepted Payment Type: T/T,PayPal,Cash;
Language Spoken:English,Chinese
We Recommend
New Arrivals
New products from manufacturers at wholesale prices


















